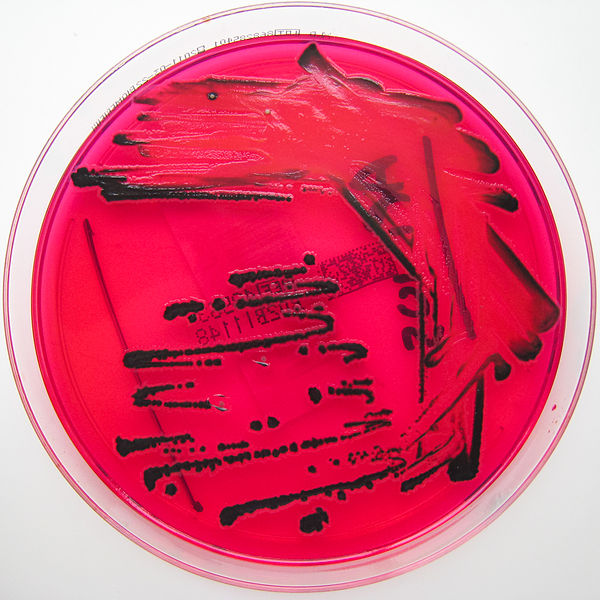
600pxSalmonella_species_growing_on_XLD_agar__Showing_H2S_production.jpg

Medical Microbiology, Salmonellae and Shigellae/ Microbiologia medica, Salmonelle e Shigelle
Salmonellae
Characteristics
Universally known to cause typhus, Salmonellae are Gram-negative enteropathogens in the shape of rods.
They are mobile thanks to the scourges arranged all over the body and grow well even in soils containing bile salts (so much so that they are able to grow well even within the gallbladder).
There are two main groups:
Ubiquitous variants:
Spread in nature through animals (zoonoses), especially birds but also rodents or pigs, so not adapted to humans, adhere very well to the intestinal mucosa. Examples are
Salmonella Choleraesuis: famous for causing cholera in pigs and therefore destruction on farms. For humans it causes gastroenteritis.
Salmonella Typhimurium: very developed in rural areas, it is vectorized by rodents. It also causes gastroenteritis to humans.
Salmonella Enteritidis: it spreads through all species of birds, especially pigeons. Infection from the environment through faecal material or contaminated food. It causes, like the previous ones, salmonellosis, which involves gastroenteritis with diarrhoea (in a week you can lose 7/8 kg).
Suitable for humans: cause systemic diseases that are not limited to trivial gastroenteritis because the intestine is only a transit area, and then invade the blood and organs. This category is only transmitted from man to man and they are part of it:
Salmonella Typhi: causes typhus.
Salmonella Paratyphi: has always been much less aggressive and causes parathyphus. It has three serotypes: A, B, C.
Pathologies caused by Salmonella adapted to humans
Typhoid is a systemic disease caused by the agent Salmonella Typhi which, prior to antibiotic use, killed about 40% of infected individuals. It is contracted oro-fecally through food or drink containing contaminated faeces.
Resistant to the acidity of gastric juices, the first site reached is the intestine, within which along its entire length, from small to large, because Salmonella Typhi has no problems of resistance to spilled bile salts, here colonizes all the mucous membrane and invades the intestinal lymph nodes.
Phagocytes in the lymphatic tract (mesenteric lymph nodes, Peyer's plaques) and in the colon phagocyte bacteria, but thanks to the very resistant and developed capsule the latter inhibit the formation of phagolisosome.
The result is that Salmonella replicate and expand within the phagocyte, which, not exposing any signal for an adaptive immune response, leaves the intestine and enters the blood carrying the bacterium throughout the body (the adaptation to humans consists in not being killed thanks to resistance to phagocytes). It can happen that Salmonellas cause lysis of the phagocyte, and are released. So we have two possibilities:
- If they are released into the blood they can be immediately captured and killed by the cells of the immune system, because the blood is a sterile district, that is, with very powerful antibacterial properties.
- If they are released from the phagocytes within the organs, they are attacked not by mobile phagocytes, but by tissue immune cells with the same function, such as reticulo-endothelial cells. Even within these phagocytes the Salmonellae replicate and with time the bacteremia becomes a real sepsis, also because the killed Salmonellae release endotoxins. These latter cause the fever to rise, according to a trend that can be depicted through a
graph with characteristic "saw-tooth" trend
The fever rises in the evening and falls in the morning, and then rises to higher levels so that in 4/5 days you can reach 40 degrees. After this period we talk about sepsis itself. The temperature stops and remains around 40 degrees for about two weeks. In the past, children and the elderly died from dehydration and asthenia, while only a few constitutionally strong adults began to react thanks to the intervention of phagocytes that were able to digest the bacteria forming the phagolisosome.
Sepsis spreads in all organs, returning to the intestine retrogradally (blood), in particular returns to the level of intestinal lymphatic stations where the disordered intervention of immune cells causes the production of pus (the bacterium dies along with the surrounding tissue and is poured outside). This leads to colliquation (liquefaction) of the lymph nodes; consequently, the infection is transmitted to the peritoneum into which the faecal material is also poured through an intestinal perforation causing peritonitis and then death in a short time.
Then the death occurred by dehydration or asthenia, or by intestinal perforation and peritonitis. Those who were able to recover thanks to a strong immunity saw the fever suddenly fall.
The paratyphe, on the other hand, had clinical manifestations similar to typhoid but much more attenuated and free of complications. In fact, unlike the tifi they cannot cause peritonitis, as they are less aggressive and less prone to block the phenomena of phagocytosis. Patients with paratyphores could only die from dehydration or asthenia.
Resolution
Antibiotic therapies have made the complications (peritonitis) disappear, making typhoid much more attenuated and much more similar to paratyphoid. Tetracyclines, chloramphenicol, quinolones and β-lactams are all antibiotics used, although they are less efficient when the bacterium is endocellular.
Antipyretics, on the other hand, have made fever more controllable.
Antibiotics, however, even after weeks of therapy, do not completely eradicate the infection and Salmonella can settle in the gallbladder where they alkalinize the bile causing gallstones after years. The subject becomes a healthy carrier and expels the bacteria through the faeces, thus being able to infect healthy individuals.
Isolation of bacteria
Since these are gram-negative sticks that are very mobile because of the scourges, it is very difficult to isolate the Salmonellas adapted to man because they do not reside in the intestine and do not cause diarrhoea and are not found in the faeces. On the contrary, they are more easily found in the blood and must be taken during the febrile peaks, and then cultivated with blood culture.
It is for this reason that a serological test for the diagnosis of typhoid and paratyphoid has been developed: in fact we produce antibodies against salmonella and these are visible following an agglutination reaction.
Widal's reaction is an agglutination reaction that uses thermostable O somatic antigens (all the others are in fact degraded after boiling the bacteria at 100°), which are first put in water where they form a whitish broth and then joined to the individual's serum. If the serum contains specific antibodies, agglutination will occur, visible through the formation of lumps. Depending on whether the lumps are in the latex of Salmonella Typhi or in that of one of the three Salmonella Paratyphi, I can understand which bacterium it is. You can also use live bacteria, which express the antigens Vi (typical only of Salmonella Typhi, correspond to the K of enterobacteria) and H, but the agglutination reaction is weaker and less visible. The agglutination titer is positive if it is greater than 1:50 (serum:broth) [microliters].
When, on the other hand, the Salmonellas want to be isolated from the faeces (therefore those not adapted to man), the liquid diarrhoeal portion is taken and placed in a sodium selenite broth for 24 hours. This stops the growth of all enteric bacteria but not the salmonellae that will continue to grow; the broth will then be sown in appropriate soils such as:
Agar Hektoen: allows all enterobacteria to grow due to the low concentration of bile salts.
Agar SS: more selective for both Salmonella and Shigella, with a concentration of double bile salts of Hektoen.
Brilliant green Agar: specific only for Salmonella, toxic to all other bacteria.
The colonies appear not salmon pink (typical of lactose fermenting bacteria) or beige (typical of other non fermenting bacteria), but black because Salmonella is able to produce H2S (hydrogen sulphide) which precipitates the iron salts present in the soil of Hektoen but also in SS soil; these iron salts are inserted into the colony that becomes completely black.
Subjects at risk
The most common form is the Salmonella enteritidis, also widespread in cities of art because of pigeons or gulls, but in rural areas also the Salmonella typhimurium, transmitted by rodents.
At risk are all those who consume food contaminated with a high number of Salmonella, especially the most delicate individuals (children under five years and elderly people over eighty) or with low levels of gastric acid and immunocompromised.
Also at risk are those who travel in hot areas (because they consume more vegetables potentially contaminated with infected water) and poorly developed from the health and hygiene point of view (Egypt, India, Thailand, ...).
Shigelle
Characteristics
Unlike Salmonellas, Shigellas are only inter-human (they are diffusible only between man and man). If the Salmonellas are the counterpart to the enteropathogenicity of the Coli (adhesiveness to the villi and impossibility to absorb water), the Shigellas represent the very serious counterpart to the enteroinvasiveness: they are Gram-negative bacilli able to perforate the intestine causing dysentery (feces with live blood, mucus and pus).
Serogroups:
A: Shigella Dysenteriae, is the most aggressive.
B: Shigella Flexneri
C: Shigella Boydii
D: Shigella Sonnei
Epidemiology is not yet fully understood, as shigellosis is distributed like a leopard and many serotypes suddenly disappear: from the 50s until today the Dysenteriae has disappeared, but it could reappear at any moment.
The spread affects the entire intestine, from small to large (these microorganisms are not afraid of bile salts) and here remains limited because the Shigellae are not resistant to phagocytosis.
Manifestations
Bacillar dysentery is much more severe than salmonellosis caused by species not adapted to humans. It contracts oro-fecally; symptoms are limited in the intestine and include violent discharges of dysentery (pus, blood and mucosa), mild fever, headache, abdominal pain and prostration.
Shigella Dysenteriae is an enterohaemorrhagic disease because it releases an enterotoxin called "Shiga toxin", which can inhibit protein synthesis in endothelials of various target organs, also acting as a neurotoxin. The toxin, composed of two subunits, in fact acts at the ribosomal level: the subunit B binds to the receptor, while the A enters the cell inactivating the factor of ribosomal elongation. The toxin is transferred from a donor to an acceptor and its diffusion can affect the glomerular cells of the kidney and brain cells,the structure of the toxin is shown in the following image.
It can also cause uremic-hemolytic syndrome, a rare disease also caused by other enterohaemorrhagic enterobacteria such as Coli Killer (capable of producing large amounts of Shiga-like toxin), and in severe cases brain haemorrhages. Infected patients die from cerebral ischaemia, intestinal perforations and peritonitis.
All other Shigellas give an intestinal infection with important local repercussions with bacillar dysentery, but less severe than the Shigella dysenteriae (no cerebral impairment or uremic-hemolytic syndrome).
As part of the Shigella infection, it enters the cells of the intestine that also make up the villi, invade them passing from one cell to the other neighbors, causes infection in all cells in the area, the phagocytes that kill the bacterium but also die from several toxic factors: the entire system dies forming pus. The mucous membranes that fall apart form the mucus, while under them there is the pus that ends up in the stool.
Differences with other enterobacteria
The difference compared to the Coli is in the distribution site, which in their case only affects the terminal portion of the intestine, while the Shigellas occupy it all. In intestinal perforations in which the mucous membrane breaks up completely, subjects are in great difficulty (they can no longer drink or eat) precisely because the damage has complete extension.
Unlike Salmonella Typhi and Paratyphi, which penetrate between the mucosal and submucosal cells leaving them intact and without repercussions on the intestine, and unlike the other Salmonella, which cover the mucous membrane preventing the reabsorption of water and causing gastroenteritis, the Shigellas enter the cells and destroy them, are captured by phagocytes that die, but do not go into circulation: they do not exceed the basal membrane and stop in the submucosa. This is where the pus originates, which will then be eliminated by means of the stool.
Therapy
- Supporting therapy
- For severely ill patients or patients at risk, a fluoroquinolone, azithromycin, or 3rd generation cephalosporin
Antidiarrheal agents (e.g. loperamide) can prolong the disease and should not be used.
Antibiotics can reduce the symptoms and elimination of Shigella but are not necessary for healthy adults with mild illness. However, some patients, including the following, should
usually be treated:
- Children
- Elderly
- Debilitated patients
- Patients with moderate to severe disease
For adults, the following antibiotic regimens may be used:
- A fluoroquinolone (as ciprofloxacin 500 mg PO every 12 h for 3 to 5 days)
- Azithromycin 500 mg PO on the first day and 250 mg 1 time/day for 4 days
- Ceftriaxone 2 g/day EV for 5 die
Salmonelle
Caratteristiche
Universalmente note per provocare il tifo, le Salmonelle sono enteropatogeni Gram-negativi a forma di bastoncello.
Sono mobili grazie ai flagelli disposti su tutto il corpo e crescono bene anche in terreni contenenti sali biliari (tant’è che sono in grado di crescere bene anche all’interno della colecisti).
Ne esistono due gruppi principali :
Varianti ubiquitarie:
Diffuse in natura tramite animali (zoonosi), soprattutto volatili ma anche roditori o suini, perciò non adattate all'uomo, aderiscono molto bene alla mucosa intestinale. Esempi ne sono:
• Salmonella Choleraesuis: famosa per causare colera nei suini e quindi distruzione negli allevamenti. Per l’uomo è causa di gastroenteriti.
• Salmonella Typhimurium: molto sviluppata nelle zone rurali, è vettoriata dai roditori. Anch’essa causa all’uomo gastroenteriti.
• Salmonella Enteritidis: si diffonde tramite ogni specie di volatili, soprattutto piccioni. Ci si infetta dall'ambiente mediante materiale fecale o cibo contaminato. Causa, come le precedenti, salmonellosi che comporta gastroenteriti con diarrea (in una settimana si può arrivare a perdere 7/8 kg).
Adattati all'uomo: causano malattie sistemiche che non si limitano a banali gastroenteriti poiché l’intestino rappresenta solo una zona di passaggio, per poi invadere il sangue e gli organi. Questa categoria si trasmette solo da uomo a uomo e ne fanno parte:
• Salmonella Typhi: causa il tifo.
• Salmonella Paratyphi: è da sempre molto meno aggressiva e causa il paratifo. Presenta tre sierotipi: A, B, C.
Patologie causate da Salmonelle adattate all'uomo
Il tifo è una malattia sistemica causata dall'agente Salmonella Typhi che prima dell'uso antibiotico portava a morte circa il 40% degli individui infetti. Si contrae per via oro-fecale tramite cibo o bevande contenenti feci contaminate.
Resistente all’acidità dei succhi gastrici, il primo sito raggiunto è l'intestino, all’interno del quale lungo tutta la sua lunghezza, dal tenue al crasso, poiché Salmonella Typhi non ha problemi di resistenza ai sali biliari riversati; qui colonizza tutta la mucosa ed invade i linfonodi intestinali.
I fagociti nel tratto linfatico (linfonodi mesenterici, placche del Peyer) e nel colon fagocitano i batteri, ma grazie alla capsula molto resistente e sviluppata questi ultimi inibiscono la formazione del fagolisosoma.
Il risultato è che le Salmonelle si replicano e si espandono all'interno del fagocita che, non esponendo alcun segnale per una risposta immunitaria adattativa, lascia l’intestino ed entra nel sangue portando il batterio in tutto il corpo (l'adattamento all'uomo consiste proprio nel non venir ucciso grazie alla resistenza ai fagociti). Può accadere che le Salmonelle provochino lisi del fagocita, e vengano liberate. Abbiamo allora due possibilità:
• Se vengono liberate nel sangue possono venire subito captate ed uccise dalle cellule del sistema immunitario, poiché il sangue è un distretto sterile, cioè con potentissime proprietà antibatteriche.
• Se vengono liberate dai fagociti all'interno degli organi, esse vengono attaccate non da fagociti mobili, ma da cellule immunitarie tissutali con stessa funzione, come le cellule reticolo-endoteliali. Anche all’interno di questi fagociti le Salmonelle si replicano e con il tempo la batteriemia diventa una sepsi vera e propria, anche perché le Salmonelle uccise rilasciano endotossine. Queste ultime fanno salire la febbre, secondo un andamento che può essere raffigurato attraverso un
grafico con andamento caratteristico “dai denti a sega”
La febbre sale la sera e scende la mattina, per poi risalire a livelli più alti tanto che in 4/5 giorni si arriva ai 40 gradi. Trascorso tale periodo si parla di sepsi vera e propria. La temperatura si ferma e resta intorno ai 40 gradi per circa due settimane. In passato bambini ed anziani morivano per disidratazione e astenia, mentre solo pochi adulti costituzionalmente forti cominciavano a reagire grazie all'intervento di fagociti che riuscivano a digerire i batteri formando il fagolisosoma.
La sepsi si diffonde in tutti gli organi, tornando all'intestino per via retrograda (ematica), in particolare ritorna a livello delle stazioni linfatiche intestinali dove l'intervento disordinato delle cellule immunitarie causa la produzione di pus (il batterio muore insieme al tessuto circostante e viene riversato all’esterno). Ciò porta a colliquazione (liquefazione) dei linfonodi; di conseguenza l'infezione si trasmette al peritoneo all’interno del quale viene riversato anche il materiale fecale tramite una perforazione intestinale causando una peritonite e quindi morte in breve tempo.
Quindi la morte avveniva per disidratazione o astenia, oppure per perforazione intestinale e peritonite. Chi riusciva a riprendersi grazie ad un’immunità forte vedeva la febbre scendere improvvisamente.
Il paratifo invece aveva manifestazioni cliniche simili al tifo ma molto più attenuate e prive di complicanze. Infatti a differenza dei tifi non riescono a causare peritonite, in quanto meno aggressivi e meno inclini a bloccare i fenomeni di fagocitosi. I pazienti affetti da paratifo potevano morire solo per disidratazione o astenia.
Risoluzione
Le terapie antibiotiche hanno fatto scomparire le complicanze (peritonite) facendo diventare il tifo molto più attenuato e molto più simile al paratifo. Tetracicline, cloramfenicolo, chinoloni e β-lattamici sono tutti antibiotici utilizzati, anche se sono meno efficienti quando il batterio è endocellulare.
Gli antipiretici invece hanno permesso di rendere la febbre più controllabile.
Gli antibiotici però, anche dopo settimane di terapia, non eradicano totalmente l'infezione e le Salmonelle possono stanziarsi nella colecisti dove alcalinizzano la bile causando dopo anni calcoli biliari. Il soggetto diventa un portatore sano e tramite le feci espelle i batteri, potendo così infettare individui sani.
Isolamento dei batteri
Trattandosi di bastoncelli gram-negativi molto mobili per via dei flagelli, è molto difficile isolare le Salmonelle adattate all'uomo perché non risiedendo nell'intestino non causano diarrea e non si trovano nelle feci. Si riscontrano invece più facilmente nel sangue e vanno prelevate durante i picchi febbrili, per poi essere coltivate con emocoltura.
È per questo motivo che è stato messo a punto un test sierologico per la diagnosi di tifo e paratifo: infatti noi produciamo anticorpi contro le salmonelle e questi sono visibili in seguito ad una reazione di agglutinazione.
La reazione di Widal è una reazione di agglutinazione che sfrutta gli antigeni termostabili O somatici (tutti gli altri sono infatti degradati dopo la bollitura a 100° dei batteri), che vengono prima messi in acqua dove formano un brodo biancastro e poi uniti al siero dell'individuo. Se quest'ultimo conterrà anticorpi specifici si verificherà l'agglutinazione, visibile tramite la formazione di grumi. A seconda che i grumi siano nel lattice della Salmonella Typhi o in quello di uno delle tre Salmonelle Paratyphi, posso capire di quale batterio si tratta. Si possono anche utilizzare batteri vivi, che esprimono gli antigeni Vi (propri solo di Salmonella Typhi, corrispondono ai K degli enterobatteri) e H, ma la reazione di agglutinazione è più debole e meno visibile. Il titolo agglutinante è positivo se maggiore di 1:50 (siero:brodo) [microlitri]
Quando invece le Salmonelle si vogliono isolare dalle feci (quindi quelle non adattate all'uomo), si prende la porzione diarroica liquida e la si mette in un brodo al selenito di sodio per 24 ore. Questo blocca la crescita di tutti i batteri enterici ma non le salmonelle che continueranno a crescere; il brodo verrà poi seminato in terreni appropriati come:
• Agar Hektoen: permette di far crescere tutti gli enterobatteri data la scarsa concentrazione di sali biliari.
• Agar SS: più selettivo sia per le Salmonelle che per le Shigelle, con concentrazione di sali biliari doppie dell’Hektoen.
• Agar verde brillante: specifico solo per le Salmonelle, tossico per tutti gli altri batteri.
Le colonie appaiono non rosa salmone (tipiche dei batteri fermentanti il lattosio) o beige (tipiche di altri batteri non fermentanti), ma nere perché Salmonella è in grado di produrre H2S (Idrogeno solforato) che fa precipitare i sali di ferro presenti nel terreno di Hektoen ma anche in terreno SS; questi sali di ferro vanno ad inserirsi nella colonia che diventa completamente nera.
Soggetti a rischio
La forma più comune è la Salmonella enteritidis, diffusa anche nelle città d’arte per via di piccioni o gabbiani, ma nelle aree rurali anche la Salmonella typhimurium, trasmessa da roditori.
A rischio sono tutti coloro che consumano cibi contaminati con elevato numero di Salmonelle, in particolar modo gli individui più delicati (bambini sotto i cinque anni e anziani sopra gli ottanta) o con ridotti livelli di acido gastrico e gli immunocompromessi.
A rischio è anche chi viaggia in aree calde (perché si consumano di più verdure e ortaggi potenzialmente contaminati con acqua infetta) e poco sviluppate sotto il profilo igienico sanitario (Egitto, India, Tailandia, …).
Shigelle
Caratteristiche
A differenza delle Salmonelle, le Shigelle sono solo interumane (sono diffusibili solo tra uomo e uomo). Se le Salmonelle sono la controparte all’enteropatogenicità del Coli (adesività ai villi e impossibilità di riassorbire acqua), le Shigelle ne rappresentano la gravissima controparte all’enteroinvasività: sono bacilli Gram-negativi in grado di perforare l’intestino causando dissenteria (feci con sangue vivo, muco e pus).
Sierogruppi:
A: Shigella Dysenteriae, è la più aggressiva.
B: Shigella Flexneri
C: Shigella Boydii
D: Shigella Sonnei
L'epidemiologia non è ancora totalmente compresa, in quanto le shigellosi si distribuiscono a macchia di leopardo e molti sierotipi scompaiono improvvisamente: dagli anni ’50 ad oggi la Dysenteriae è sparita, ma potrebbe ricomparire da un momento all’altro.
La diffusione interessa l'intero intestino, dal tenue al crasso (tali microorganismi infatti non temono i sali biliari) e qui vi resta limitata perché le Shigelle non sono resistenti alla fagocitosi.
Manifestazioni
La dissenteria bacillare è molto più grave rispetto alla salmonellosi causata dalle specie non adattate all'uomo. Si contrae per via oro-fecale; la sintomatologia è limitata a livello intestinale e comprende violente scariche di dissenteria (pus, sangue e mucosa), febbre lieve, cefalea, dolori addominali e prostrazione.
La Shigella Dysenteriae è un enteroemorragico in quanto rilascia un’enterotossina detta “tossina di Shiga”, in grado di inibire la sintesi proteica in endoteli di vari organi bersaglio, funzionando anche da neurotossina. La tossina, composta da due subunità, infatti agisce a livello ribosomiale: la subunità B si lega al recettore, mentre la A entra nella cellula inattivando il fattore di elongazione ribosomiale. La tossina si trasferisce da un donatore ad un accettore e la sua diffusione può interessare le cellule glomerulari del rene e le cellule cerebrali, la struttura della tossina è riportata nell'immagine seguente.
Può anche causare la sindrome uremico-emolitica, malattia rara causata anche da altri enterobatteri enteroemorragici come i Coli Killer (in grado di produrre grandi quantità di tossina Shiga-like), e nei casi più gravi emorragie cerebrali. I pazienti infettati muoiono per ischemia celebrale, perforazioni intestinali e peritoniti.
Tutte le altre Shigelle danno un’infezione intestinale con importanti ripercussioni a livello locale con dissenteria bacillare, ma meno gravi della Shigella dysenteriae (non comporta compromissione cerebrale né sindrome uremico-emolitica).
Nell’ambito dell’infezione da Shigella, essa entra nelle cellule dell’intestino che compongono anche i villi, le invadono passando anche da una cellula alle altre vicine, provoca infezione in tutte le cellule della zona, intervengono i fagociti che uccidono il batterio ma muoiono anch’essi per diversi fattori tossici: l’intero sistema muore formando pus. Le mucose che si sfaldano vanno a costituire il muco, mentre sotto di esse si trova il pus che finisce nelle feci.
Differenze con altri enterobatteri
La differenza rispetto ai Coli consiste nella sede di distribuzione, che nel loro caso interessa soltanto la porzione terminale dell'intestino, mente le Shigelle lo occupano tutto. Nelle perforazioni intestinali in cui la mucosa si sfalda completamente i soggetti sono in grande difficoltà (non riescono più a bere né a mangiare) proprio perché il danno ha completa estensione.
A differenza di Salmonella Typhi e Paratyphi che penetrano tra le cellule di mucosa e sottomucosa lasciandole integre e senza dare ripercussioni sull’intestino e a differenza delle altre Salmonelle che tappezzano la mucosa impedendo il riassorbimento di acqua e causando gastroenteriti, le Shigelle entrano nelle cellule e le distruggono, vengono captate dai fagociti che muoiono, ma non vanno in circolo: non superano la membrana basale e si fermano nella sottomucosa. Qui si origina il pus che sarà poi eliminato tramite le feci.
Terapia
• Terapia di supporto
• Per i pazienti gravemente malati o a rischio, un fluorochinolone, azitromicina, o cefalosporina di 3a generazione
Gli agenti antidiarroici (p. es., loperamide) possono prolungare la malattia e non devono quindi essere usati.
Gli antibiotici possono ridurre i sintomi e l'eliminazione di Shigella ma non sono necessari per gli adulti sani con malattia in forma lieve. Tuttavia, alcuni pazienti, compresi i seguenti, devono
solitamente essere trattati:
• Bambini
• Anziani
• Pazienti debilitati
• Pazienti con malattia da moderata a grave
Per gli adulti, possono essere utilizzati i seguenti regimi antibiotici:
• Un fluorochinolone (come ciprofloxacina 500 mg PO ogni 12 h per 3 a 5 giorni)
• Azitromicina 500 mg PO il primo giorno e 250 mg 1 volta/die per 4 die
• Ceftriaxone 2 g/die EV per 5 die
Fonti/Sources
Immagini/Pictures

These are organisms we would isolate and send out to state lab. We do not do identification at the species level.
Another random fact: the MALDI-TOF generally cannot tell the difference between E. coli and Shigella. So, always check your cultures and other media before freaking out. Although, chances are, it's probably E. coli.
Hello,
Your post has been manually curated by a @stem.curate curator.
We are dedicated to supporting great content, like yours on the STEMGeeks tribe.
Please join us on discord.
Congratulations @riccc96! You have completed the following achievement on the Steem blockchain and have been rewarded with new badge(s) :
You can view your badges on your Steem Board and compare to others on the Steem Ranking
If you no longer want to receive notifications, reply to this comment with the word
STOPTo support your work, I also upvoted your post!
This post was selected, voted and shared by the discovery-it curation team in collaboration with the C-Squared Curation Collective. You can use the #Discovery-it tag to make your posts easy to find in the eyes of the curator. We also encourage you to vote @c-squared as a witness to support this project.